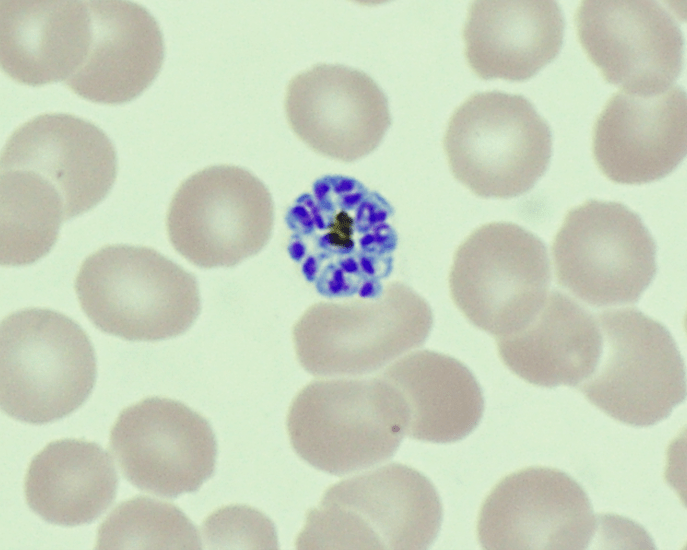

Case Description
A 36 year old male presented to the emergency department with complaints of fevers, chills, night sweats, nausea, diarrhea, weakness, and decreased appetite for 6 days. He often travels between India and Dallas, and five months prior to presentation returned from two years abroad. While overseas, he developed similar symptoms, but due to COVID-19 restrictions, he was unable to see a provider at that time. His family doctor prescribed a course of medication for presumed malaria, which he completed but could not recall the name of the medication. He endorsed being ill for two weeks at that time and improved with medication to complete resolution of his symptoms. Prior to presentation, he also endorsed 3-4 episodes of non-bloody diarrhea per day and remembered a period of self-resolving chills a month prior. His fever and rigors were cyclic, occurring every other day, worsening up to presentation.
Given his travel history and symptomology, blood was drawn in the emergency department for analysis including a malaria smear. CBC and CMP were significant for elevated bilirubin (Total bilirubin 1.6 mg/dL, Direct bilirubin 0.4 mg/dL), leukopenia (3.60 x 10(9)/L), macrocytosis (92.5 femtoliters), thrombocytopenia (86 x 10(9)/L), and elevated CRP (6.6 mg/dL). His blood differential was significant for neutrophilia (91%), lymphocytopenia (7%), and monocytopenia (1%). The malaria smear was positive, and the patient was given a dose of artemether/lumefantrine in the emergency department. Plasmodium vivax was identified at a parasitemia of 0.5% (Figure 1), and the infectious disease service recommended admission for further workup including testing for G6PD deficiency prior to starting primaquine. He was not G6PD deficient, and an ultrasound of the spleen was unremarkable. The patient was treated with chloroquine for the erythrocytic and primaquine for the exo-erythrocytic stages of P. vivax malaria.

Discussion
Malaria is an infection caused by protozoan parasites of the genus Plasmodium. These organisms are transmitted by female Anopheles mosquitos upon taking a blood-meal. Human malaria is caused by five defined Plasmodium species: P. falciparum, P. vivax, P. ovale, P. malariae, and P. knowlesi.1 While not endemic to the United States, there is significant disease burden worldwide. In 2019, an estimated 230 million cases of malaria were reported causing approximately 409,000 deaths.2
The two lifecycles of Plasmodium sp. in the human host are classically defined as “erythrocytic” and “exo-erythrocytic”, involving red blood cells and hepatocytes, respectively. Plasmodium sporozoites are inoculated into the human host from the salivary glands of the mosquito upon feeding. From there, the sporozoites travel to the liver where they infect hepatocytes, mature into schizonts and ultimately merozoites. The infected hepatocyte then ruptures, releasing merozoites which enter the circulation and infect erythrocytes, initiating the erythrocytic cycle. This is a unifying trait of all Plasmodium sp. causing human malaria. Importantly, P. vivax and P. ovale form hypnozoites (dormant forms) in the liver, which can reactivate (oftentimes months to years later) following bloodstream clearance, resulting in relapse. It is therefore important that Plasmodium sp. infections be accurately speciated, as management of liver stage parasites differs from that of those in the bloodstream. By contrast, P. malariae and P. falciparum do not form hypnozoites and thus do not chronically infect the liver.
Plasmodium speciationis accomplished by evaluating thin and thick blood spears,4 allowing for assessment of parasite morphology and determination of parasitemia to guide patient management. In cases of P. vivax, the red blood cells are often enlarged (1.5 to 2 times the size of uninfected erythrocytes). Ring forms in all stages of development can be observed in P. vivax infection. These ring forms subsequently mature into trophozoites or gametocytes. P. vivax trophozoites exhibit a large, amoeboid cytoplasm, large chromatin dots, and fine yellow-brown pigment. Trophozoites subsequently develop into schizonts in the infected erythrocytes, subsequently rupturing leading to autoinfection. P. vivax schizonts are large with coalesced pigment and harbor 12 or more merozoites3 (Figure 2). P. vivax gametocytes are large and round to oval shaped and have scattered brown pigment, hemozoin, that may fill the erythrocyte (Figure 3). Gametocytes will migrate to the capillaries which are taken up by a mosquito upon taking a blood-meal, completing the Plasmodium lifecycle.

Here we present a case of relapsed P. vivax infection. Blood stage P. vivax parasites are susceptible to chloroquine, but dormant hypnozoites in the liver are resistant to its effects. Hypnozoites can be treated with primaquine, and thus routine management of either P. ovale or P. vivax usually consists of a combination of both antimalarial drugs. It is important to note that primaquine is contraindicated in cases of G6PD deficiency and pregnancy due to hemolytic complications,2 which is why this patient was tested prior to initiating therapy.
P. vivax has a worldwide distribution but has higher prevalence in colder climates as compared to other malaria species. P. vivax is most commonly encountered in Latin America and Southeast Asia. In addition to colder climate adaptation, P. vivax is interesting in that the parasite uses Duffy red cell antigens to enter erythrocytes and in populations with low frequency of Duffy on the surface of RBCs those groups are generally resistant to P. vivax infection. However, there have been rare cases of P. vivax in Africans who are Duffy-null.5
References
- Gladwin, M., Mahan, C. S., & Trattler, B. (2021). Malaria. In Clinical microbiology made ridiculously simple (pp. 343–346). essay, MedMaster, Inc.
- Menkin-Smith L, Winders WT. Plasmodium Vivax Malaria. [Updated 2021 Jul 23]. In: StatPearls [Internet]. Treasure Island (FL): StatPearls Publishing; 2021 Jan-. Available from: https://www.ncbi.nlm.nih.gov/books/NBK538333/
- Procop, G. W., Koneman, E. W., & Winn, W. C. (2017). Malaria. In Koneman’s color Atlas and textbook of diagnostic microbiology (pp. 1467–1470). essay, Lippincott Williams & Wilkins.
- Laboratory diagnosis of malaria: Plasmodium vivax. Laboratory Identification of Parasites of Public Health Concern. (n.d.). Retrieved September 14, 2021, from https://www.cdc.gov/dpdx/resources/pdf/benchAids/malaria/Pvivax_benchaidV2.pdf.
- Gunalan, K., Niangaly, A., Thera, M. A., Doumbo, O. K., & Miller, L. H. (2018). Plasmodium vivax infections of duffy-negative erythrocytes: Historically undetected or a recent adaptation? Trends in Parasitology, 34(5), 420–429. https://doi.org/10.1016/j.pt.2018.02.006
-Elisa Lin is a fourth-year medical student at UT Southwestern Medical Center in Dallas, Texas. She is interested in AP/CP track residencies.

-Clare McCormick-Baw, MD, PhD is an Assistant Professor of Clinical Microbiology at UT Southwestern in Dallas, Texas. She has a passion for teaching about laboratory medicine in general and the best uses of the microbiology lab in particular.

-Andrew Clark, PhD, D(ABMM) is an Assistant Professor at UT Southwestern Medical Center in the Department of Pathology, and Associate Director of the Clements University Hospital microbiology laboratory. He completed a CPEP-accredited postdoctoral fellowship in Medical and Public Health Microbiology at National Institutes of Health, and is interested in antimicrobial susceptibility and anaerobe pathophysiology.